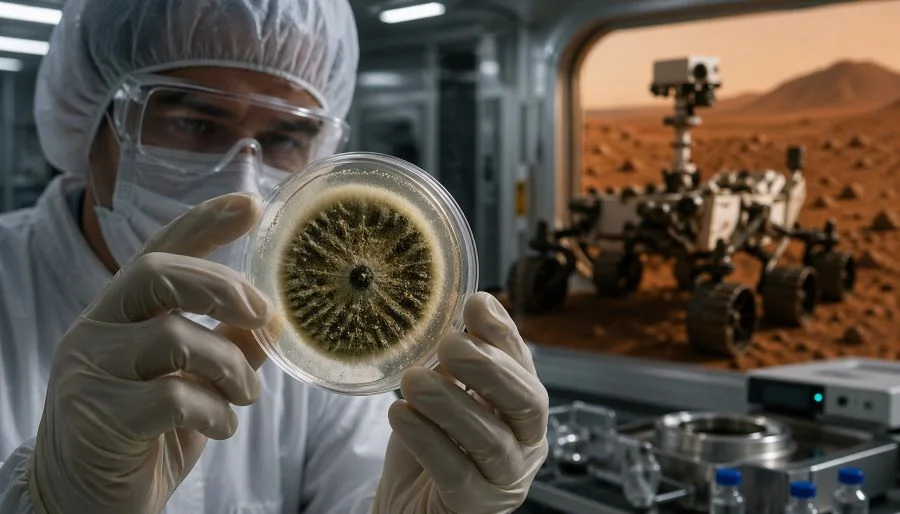
Грибы, способные выжить на Марсе: опасность для космонавтов или ключ к освоению космоса?

Главное сегодня
Сегодня, 12:59
Досрочно погасить ипотеку: скрытые риски, о которых молчат банки
Сегодня, 12:56
Грибы, способные выжить на Марсе: опасность для космонавтов или ключ к освоению космоса?
Сегодня, 12:53
Шепс в шоке: участница шоу на глазах у всей страны уличила экстрасенса в лжи о смерти её отца

Сегодня, 12:49
Кремация и вечные муки: священник объяснил, что ждёт душу после смерти

Сегодня, 12:46
ВС РФ наращивают давление по всей линии фронта: свежая сводка СВО на полдень 23 апреля 2026 года, карта боевых действий, 1519-й день операции

Сегодня, 12:31
Кому откажут, а кому дадут: новые правила детских пособий с 2026 года
23.04.26Досрочно погасить ипотеку: скрытые риски, о которых молчат банки
22.04.26С мая меняются правила выплат на детей: что важно знать каждому родителю
22.04.26ОАЭ могут начать покупать нефть за юани: доллар теряет позиции
21.04.26Цены на нефть падают: трейдеры ждут сближения США и Ирана
20.04.26Доллар растет, золото дешевеет: как конфликт США и Ирана бьет по рынкам
23.04.26Когда закончится СВО: прогнозы экспертов и сроки окончания спецоперации на Украине на 23 апреля 2026 года, последние новости
22.04.26Блокада Калининграда Германией вызовет настоящий кошмар от России
22.04.26Мир может остаться без иранской нефти: в МЭА оценили последствия конфликта
22.04.26Польша распродает золотовалютные резервы ради армии
19.04.26Иранское оружие мощнее атомного: почему весь мир боится блокады Ормузского пролива
Последние новости

Сегодня, 12:26
Цифровизация ЖКХ: как робот-взыскатель меняет правила игры для жителей России

Сегодня, 12:18
Дача–2026: почему конец апреля – ваш главный шанс в сезоне

Сегодня, 12:01
Завтракайте вовремя: как биоритмы помогают держать вес под контролем

Сегодня, 11:58
Ученые раскрыли, как кофе влияет на кишечник и наше настроение

Сегодня, 11:42
До 20 мая: 4 знака зодиака, на которых прольется река удачи

Сегодня, 11:36
Терентьев день 23 апреля: народные традиции, строгие запреты и вековая мудрость

Сегодня, 10:43
Демобилизация с СВО в 2026 году: когда мобилизованные смогут вернуться домой
Сегодня, 10:32
Обстрелы Белгородской области 23 апреля 2026 года: последствия атак, пострадавшие и обстановка в регионе

Сегодня, 10:16
Когда закончится СВО: прогнозы экспертов и сроки окончания спецоперации на Украине на 23 апреля 2026 года, последние новости
Сегодня, 09:59
Купянск, 23 апреля 2026 года: ожесточённые бои в городе и на подступах — свежая сводка с фронта и карта боевых действий
Сегодня, 09:04
Бои за Рай-Александровку усиливаются: сводка СВО Юрия Подоляки на 23 апреля

Сегодня, 08:41
Магнитная буря сегодня, 23 апреля 2026 года: прогноз, характеристика дня и рекомендации врачей
